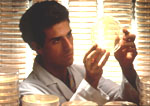
Πειραματική γονιδιακή θεραπεία κατά της καρδιακής ανεπάρκειας

Αποτελεσματική η κυτταρική θεραπεία στην αντιμετώπιση της καρδιακής ανεπάρκειας
Στοκχόλμη: Οι ασθενείς με χρόνια καρδιακή ανεπάρκεια που έχουν υποβληθεί σε μεταμόσχευση βλαστοκυττάρων από τον δικό τους μυελό των οστών έχουν καλύτερη καρδιακή λειτουργία και ζουν περισσότερο, σύμφωνα με γερμανική μελέτη.

Αριθμός Πιστοποίησης Μ.Η.Τ.232442
Αριθμός Πιστοποίησης Μ.Η.Τ.232442